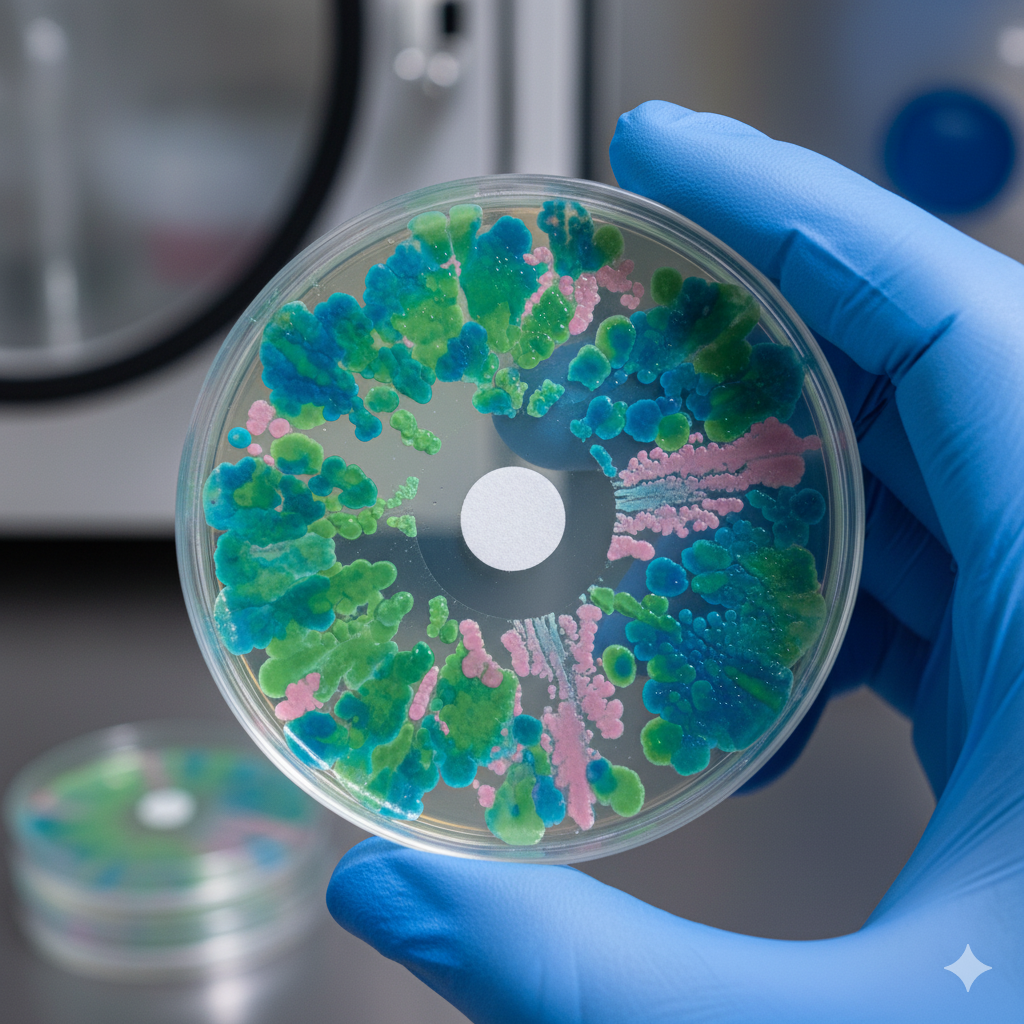
Infectious Disease
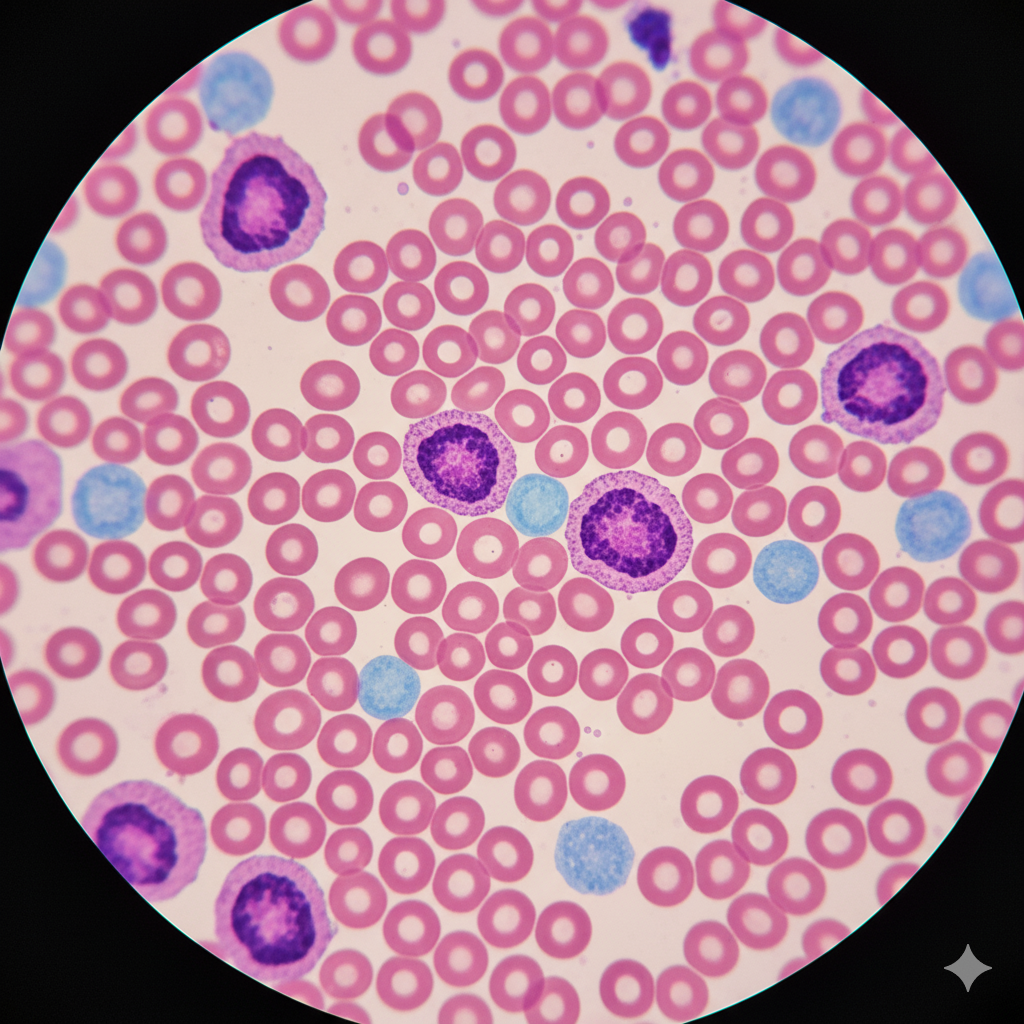
Laboratory

Specialties — End-to-end RCM
Click any service to view full scope, process, and benefits.

ABA Therapy Billing
Specialty billing expertise and payer rules mastery for ABA therapy practices.
Explore →
Acupuncture Billing
Specialty billing expertise and payer rules mastery for acupuncture practices.
Explore →
Anesthesia Billing
Specialty billing expertise and payer rules mastery for anesthesia practices.
Explore →

Behavioral Health RCM
Specialty billing expertise and payer rules mastery for behavioral health practices.
Explore →


Chiropractic Billing
Specialty billing expertise and payer rules mastery for chiropractic practices.
Explore →
Clinical Lab
Specialty billing expertise and payer rules mastery for clinical laboratories.
Explore →

Dermatology
Specialty billing expertise and payer rules mastery for dermatology practices.
Explore →


Endocrinology
Specialty billing expertise and payer rules mastery for endocrinology practices.
Explore →



Gastroenterology
Specialty billing expertise and payer rules mastery for gastroenterology practices.
Explore →
General Surgery
Specialty billing expertise and payer rules mastery for general surgery practices.
Explore →




Home Health
Specialty billing expertise and payer rules mastery for home health providers.
Explore →
Hospice Billing
Specialty billing expertise and payer rules mastery for hospice providers.
Explore →
Infectious Disease
Specialty billing expertise and payer rules mastery for infectious disease practices.
Explore →
Internal Medicine
Specialty billing expertise and payer rules mastery for internal medicine practices.
Explore →
Mental Health
Specialty billing expertise and payer rules mastery for mental health practices.
Explore →
Molecular Lab
Specialty billing expertise and payer rules mastery for molecular laboratories.
Explore →


Neurosurgery
Specialty billing expertise and payer rules mastery for neurosurgery practices.
Explore →
Nursing Home
Specialty billing expertise and payer rules mastery for nursing home facilities.
Explore →

Occupational Therapy
Specialty billing expertise and payer rules mastery for occupational therapy.
Explore →

Ophthalmology
Specialty billing expertise and payer rules mastery for ophthalmology practices.
Explore →

Pain Management
Specialty billing expertise and payer rules mastery for pain management practices.
Explore →
Pathology Lab
Specialty billing expertise and payer rules mastery for pathology laboratories.
Explore →

Physical Therapy
Specialty billing expertise and payer rules mastery for physical therapy.
Explore →
Plastic Surgery
Specialty billing expertise and payer rules mastery for plastic surgery practices.
Explore →

Primary Care
Specialty billing expertise and payer rules mastery for primary care practices.
Explore →


Pulmonology
Specialty billing expertise and payer rules mastery for pulmonology practices.
Explore →

Rheumatology
Specialty billing expertise and payer rules mastery for rheumatology practices.
Explore →
Substance Abuse Billing
Specialty billing expertise and payer rules mastery for substance abuse treatment.
Explore →
Thoracic Surgery
Specialty billing expertise and payer rules mastery for thoracic surgery practices.
Explore →
Toxicology Lab
Specialty billing expertise and payer rules mastery for toxicology laboratories.
Explore →
Traumatology
Specialty billing expertise and payer rules mastery for traumatology practices.
Explore →
Urgent Care Billing
Specialty billing expertise and payer rules mastery for urgent care centers.
Explore →

Ready to Reduce Denials and Increase Revenue?
Our denial management experts are ready to help you recover lost revenue and prevent future claim denials.
Contact Us Today